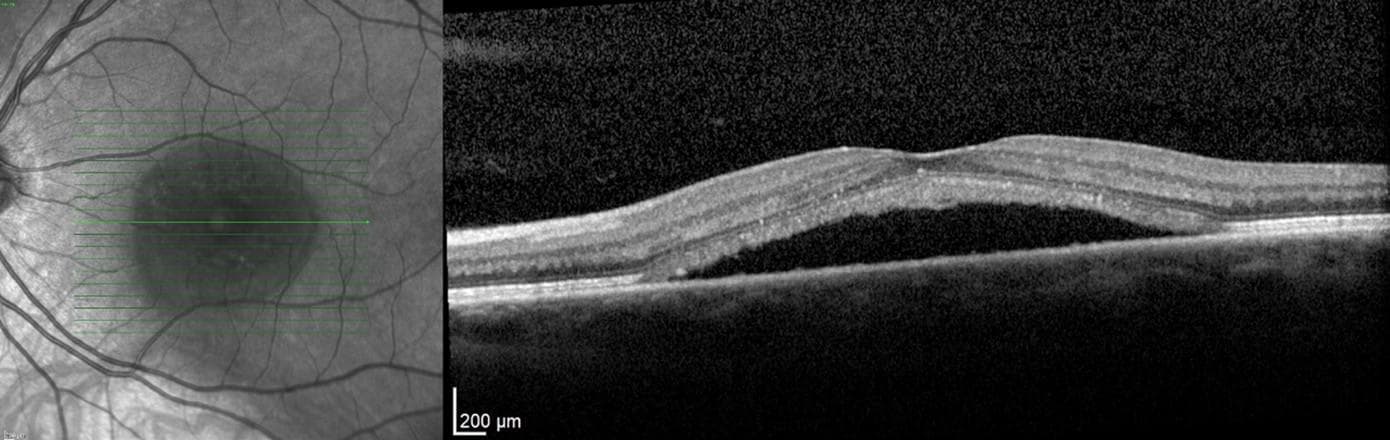
Central Serous Chorioretinopathy: Evolving Understanding, Investigations, and Treatment Options

60 articles from this collection:

mivision

THE OPHTHALMIC JOURNAL
As a team we are extremely proud to have become a leading publisher of news, research, and continued professional development for the ophthalmic profession in Australia, New Zealand and beyond.

contributors
Dr Christolyn Raj is a Melbourne-based ophthalmologist and a key figure in the field of retinal medicine. Her current research affiliation within the University of Melbourne is looking into novel therapies for the early treatment of diabetic maculopathy.

‘Significant’ Vision Restoration in Gene Therapy Trial
A mutation-agnostic gene therapy for retinitis pigmentosa has achieved “clinically meaningful vision improvement in legally blind individuals with progressive and permanent neurodegeneration of the retina”.

Conjunctival Melanoma in Australia
The incidence of conjunctival melanoma (CJM) increased in Australia during the period from 1982 to 2014; however, the survival rate remained the same at a mean of 90%, according to a new paper published in Investigative Ophthalmology and Visual Science.

ProVision Leverages Data for Member Development
ProVision is enabling optometrists to make evidence-based business decisions by leveraging valuable data about the demographics and purchasing behaviours of patients visiting their practices.

Change for Sickle Cell Disease
One in three children with sickle cell disease had retinopathy because of disease, leading to calls for more frequent eye exams for paediatric sickle cell patients.

Artificial Vitreous Body Extracted from Algae
Researchers in Korea have discovered an innovative approach to treating retinal detachment, developing an artificial vitreous body made from a substance extracted from algae.

Competency Framework for Global Optometry Launched
The World Council of Optometry (WCO) has introduced a new resource defining optometry in terms of essential competencies required to engage effectively in the international eye care agenda.

Efficacy of Water-Free Ciclosporin
Water-free ciclosporin was more effective in improving total corneal fluorescein staining (tCFS) and symptoms of dry eye disease (DED), but did not improve dryness scores, a new Chinese study has found.

Diabetes Australia Partners with Defeat Diabetes
Diabetes Australia is partnering with Defeat Diabetes to support people living with, and at risk of developing, type 2 diabetes.

FRB! Research: So Much More Than Number Crunching
Involvement in the Fight Retinal Blindness! research has fuelled Dr Adrian Hunt’s passion for science, informed the management of his patients as a retinal specialist, and helped him establish a professional network of peers interested in doing the same.

GEORGE & MATILDA EYECARE

Assisted IVI Devices Gaining Popularity
The use of injection assistance devices is increasing in popularity, according to a study of intravitreal injection (IVI) habits conducted in the United Kingdom.

New Contact Lens to Heal Eyes
A drug-delivering bandage contact lens that simultaneously treats the eye and allows it to heal faster has been developed by a cross-disciplinary team at University of Waterloo in Canada.

Music Soothes Anxiety in Cataract Surgery
A United States study has found playing patient-selected music is an inexpensive, low risk, and effective way to decrease patient anxiety during cataract surgery.

KeepSight Recognises Top-Performing Optometrist
Ipswich-based optometrist Elle Carson has been recognised by KeepSight for her commitment to supporting people living with diabetes.

AI Can Replace Human for ROP Detection: Study
Artificial intelligence (AI) technology can accurately and independently detect 100% of severe cases of a blindness-causing condition that affects prematurely born babies, according to new research out of the United States.

Ophthalmology Updates!
Registrations are open for Ophthalmology Updates! – the event billed as the ophthalmology conference with a difference that brings together the brightest minds from each ophthalmic subspecialty.

Register for AUSCRS

GenEye: The Future of Eye Health
GenEye is set to revolutionise the provision of eye health with an immersive training event, scheduled to take place from 19 June at the newly renovated and state-of-the-art Education Precinct at The Royal Victorian Eye and Ear Hospital in Melbourne.

Achieving Excellence in Patient Outcomes
Ophthalmologists from Australia, Taiwan, Singapore, Indonesia, Philippines and India came together at the Asia Pacific Academy of Ophthalmology Congress (APAO) in Bali to discuss the use of Rayner’s RayOne enhanced monovision (EMV ) intraocular lens (IOL) for optimising visual outcomes.

Affordable New Multifocal Lens from CR Labs
CR Labs has launched a new premium free form multifocal lens, Austral is Easy, combining both hard and soft design elements into one seamless solution.

O-SHOW24

Partnership Lifts Presbyopia Awareness
EssilorLuxottica and the World Council of Optometry (WCO) have announced a global partnership to raise awareness of presbyopia and the ageing eye.

Vision Australia Life Ready Hub
Vision Australia has launched its Life Ready Hub: an online learning portal for children and young people (aged 18 and under) who are blind or have low vision and their families.

Optometry Virtually Connected

Amblyopia and Risks for Adult Health
Adults who had amblyopia in childhood are more likely to experience hypertension, obesity, and metabolic syndrome in adulthood, as well as an increased risk of heart attack, according to a new study.

School Green Space Effects on Myopia
Increased green space around schools was associated with slowing myopia progression in primary school-aged children, according to researchers in China.

Protein Could Repair Optic Nerve
Researchers at the University of Connecticut (UConn) have identified a potentially transformative factor for regenerating damaged optic nerves, which they believe could one day prevent irreversible blindness.

“Transformative” Event Welcomes New EssilorLuxottica Optoms
EssilorLuxottica has welcomed its newest crop of graduate optometrists with a three-day event incorporating two days of intensive learning at its EyeLaunch conference in March.

WELCOME TO THE MACULAR DISEASE ISSUE
The results of a recent patient survey came as no surprise: we learned that 56% of patients leaving a clinic didn’t clearly understand their diagnosis, including the name of their condition. Despite the good intentions of eye health professionals, at Macular Disease Foundation Australia (MDFA), this is something we hear from people every day when they reach out to us for support.

INGRID’S STORY Navigating Retinitis Pigmentosa
Ingrid Barnes was six months off turning 25 when she experienced a rapid decline in her visual acuity. She was diagnosed with non-inherited retinitis pigmentosa soon after. It turned out that she’d been losing vision for most of her life. In fact, at the time of diagnosis, she’d already been legally blind for 10 years; she just didn’t know what she couldn’t see.

Improving Access to Outback Eye Care with Cutting-Edge Technology
With over a decade providing accessible eye care to those living in the larger regional towns of Western Australia, McCusker Director of Lions Outback Vision, Associate Professor Angus Turner is embarking on a new frontier armed with the latest technology to prevent blindness from diabetic eye disease.

Taking IVI to the People
A Sydney ophthalmologist has urged colleagues to think outside the box and consider taking sight-saving intravitreal eye injection (IVI) therapy out of the clinic when circumstances demand it.

Making Sense of the Retinal Fingerprint in Clinical Practice
A fingerprint is a unique identifier that has revolutionised security in the modern world. The retina, too, provides a similar fingerprint that can be used as a key universal identifier. Dr Christolyn Raj explains how eye health professions can harness retinal fingerprint technology for use in clinical practice.

Ophthalmology UPDATES
Www.ophthalmologyupdates.com

Ophthalmology Products
Eylea (aflibercept) binds to vascular endothelial growth factor-A (VEGF-A) and placental growth factor (PLGF) proteins.

New Evidence on Eating Patterns: Changes to AMD Nutrition Guidelines
To celebrate Macula Month, Macular Disease Foundation Australia (MDFA) has launched updated nutrition guidelines for age-related macular degeneration (AMD). The new guidelines suggest eating patterns, such as Mediterranean or Asian diets – rather than specific foods – may be a key to AMD prevention and progression. And there’s new evidence that drinking alcohol is a risk factor for developing AMD.
Central Serous Chorioretinopathy: Evolving Understanding, Investigations, and Treatment Options
Central serous chorioretinopathy (CSCR) is an idiopathic retinal disease in which fluid accumulates below the neurosensory retina, causing a serous detachment. CSCR has been typically viewed to be benign due to its self-limiting nature. However, as some cases can be chronic, management can be challenging. Over recent years there have been major evolutions in how we view and manage this classic disease, through deeper pathophysiological understandings and the availability of new treatment options and imaging tools.

Artificial Intelligence: Reshaping AMD Management
The integration of artificial intelligence (AI) into age-related macular degeneration management heralds a new era of personalised care and precision medicine. With its ability to predict disease progression, identify biomarkers, and assist in treatment decision-making, AI offers a powerful tool to enhance visual outcomes for AMD patients.

My Eyes
The new My Eyes service from Macular Disease Foundation Australia (MDFA), launching as part of Macula Month, is the first support service to enhance health outcomes for anyone living with age-related macular degeneration. My Eyes offers education, resources, and emotional support aimed at enhancing treatment adherence, fostering better selfmanagement, and ultimately improving overall wellbeing.

Faricimab
From 1 January 2023, the Pharmaceutical Benefits Scheme (PBS) approved the reimbursement of faricimab (Vabysmo, Roche/ Genentech) for the management of neovascular age related macular degeneration (nAMD) and diabetic macular oedema (DMO). It’s another proven tool for ophthalmologists.

Anatomy of the Eye
Www.anatomyoftheeye.com

Management of GA
There is hope on the horizon for up to 100,000 Australians living with geographic atrophy (GA) as the first treatments for this rapidly progressive disease are now being used overseas and are anticipated to receive regulatory approval in Australia in the near future.

Preparing for Change Updated RANZCO AMD Guidelines
With new treatments for geographic atrophy in the pipeline, Royal Australian and New Zealand College of Ophthalmologists (RANZCO) has updated the AMD referral guidelines that optometrists use to direct patient management.

INTERACTIVE EDUCATION
Www.cfeheducation.com

Epiretinal Membranes Looking Beyond the Macula
Epiretinal membranes (ERMs) are a common finding within optometric practice, with some studies reporting a prevalence of up to 34%. While many clinicians may consider an ERM a relatively benign finding, it is important to recognise that they can be associated with a plethora of vision-threatening ocular disorders

Finessing the Fit: Scleral Lenses for Keratoconus
Scleral lenses are a gamechanger for keratoconic patients, however they are not without complications, so careful fitting and regular review is essential.

Battling to be Better: Advancing Eye Research
Dr Ceecee Britten-Jones is often asked why she pursued a PhD. Despite the challenges of academia, she says studying has set her up for a truly rewarding research career.

Refreshing – and Chasing – a Vision for Optometry
What will optometry look like in 15 years? Optometry Australia’s 2040 project has been refreshed to reflect current and emerging trends.

Premium Lenses The Material Difference
When it comes to choosing lens materials to optimise our patients’ visual needs, it’s essential that we take all options into consideration. However, with so many lens materials now available, it can be tempting to fall back on a ‘go to’ selection. In doing so, we may unwittingly neglect the most advantageous option for the patient sitting in front of us. So how should we select the most appropriate lens material for each and every customer?

Heroes of Eyewear Design
Australia’s rich multiculturalism and spectacular natural landscapes inspire artists and industrial designers to create designs that celebrate and embrace different cultures and styles.

Celebrating Glamour
Jimmy Choo is a global luxury brand with a presence in more than 40 countries and a solid footprint of 281 boutiques. Founded in 1996 by bespoke shoemaker Jimmy Choo, the company grew up in the East End of London in the early 1990s. While Mr Choo departed his company in 2001, the family presence remains strong with his niece, Sandra Choi, heading up the design of all categories as Creative Director of the East End atelier. Women’s shoes remain the core of the product offering, alongside handbags, small leather goods, scarves, sunglasses, belts, fragrances, men’s shoes and, of course, eyewear. The Jimmy Choo 2024 eyewear collection recently became the new luxury addition of the EssilorLuxottica portfolio.

Lighter than Ever: Read On
Swiss eyewear designer read on has introduced read on light – ultra-thin lightweight and highly flexible reading glasses made from skin-friendly TR-90. At just 3 mm, read on light is one of the thinnest reading glass designs on the market and it’s available in contemporary designs and in five eye-catching colours. Housed in a minimalist colour-blocked hard case, read on specs come with a convenient neck /shoulder strap accessory in colours to match the frames.

mi products
Ever Clean Plus is a hydrogen peroxide system suitable for all rigid gas permeable, scleral and soft contact lenses. The bi-layer tablet contains biotechnological agents to eliminate proteins, lipids, and other deposits from the contact lens surface. In just two hours, contact lenses are disinfected, cleaned, and moisturised with the wetting agent povidone without the need to rub and rinse. The solution is neutralised and turns green due to the natural colour indicators.

Events
Events

Events
Events

O-show

Aarons
